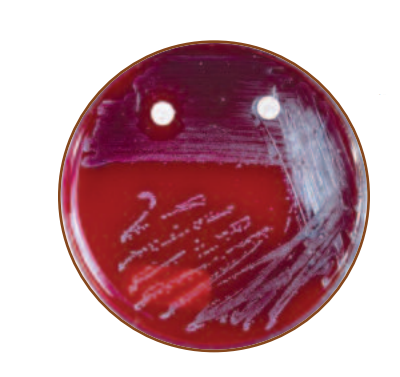
SXT and Bacitracin sensitivity test - SXT-Bacitracin test forStreptococcus pyogenes.Bacitracin is on the left (S) and SXT on the right (R)
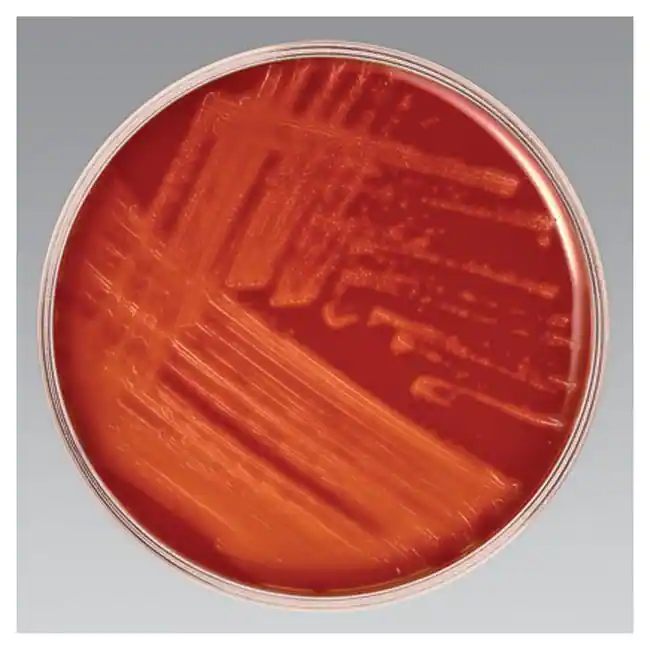
SXT Blood agar with heavy growth  - SXT Blood agar with heavy growth of beta hemolytic streptococci

SXT (sulfamethoxazole-trimethoprim) susceptibility testing differentiates group A and B streptococci from other hemolytic streptococci. Group A and B streptococci are SXT resistant, whereas other hemolytic streptococci are susceptible to SXT. Coupled with bacitracin sensitivity testing, it helps differentiate groups A and B streptococci from each other.
The addition of SXT in the 5% sheep blood agar prevents the growth of normal microbiota of the pharynx. This aids in the easy recovery of group A streptococci, especiallyStreptococcus pyogenes,and group B streptococci from throat swabs.
Principle of SXT Test
Sulfamethoxazole and trimethoprim are two antibiotics of the category co-trimoxazole. These antibiotics act synergistically (working together to give greater effect) to disrupt the folic acid metabolism of bacteria. So, they are mostly given together.
An SXT disc usually has 1.25 µg of trimethoprim and 23.75 µg of sulfamethoxazole, which is approximately in the ratio of 1:19. When the disc is placed on the surface of sheep blood agar, a clear zone around the disc is observed, which means the bacteria is susceptible to SXT. If the growth of bacteria is up to the edge of the disc, the bacteria is considered resistant to SXT. SXT and bacitracin susceptibility testing are done together by placing a disc of bacitracin and SXT on the plate at least 4 cm apart.
Materials Required for SXT Test
- 5% defibrinated blood agar plate
- Inoculating loop
- Bacterial sample
- SXT disc
- Bacitracin disc
Procedure of SXT Test
To perform SXT Test
The procedure of SXT susceptibility testing is as follows:
- Inoculate the bacterial sample in continuous streaking in a 5% defibrinated (removal of fibrin) blood agar plate using a sterile inoculating loop.
- Then carefully place the SXT antibiotic disc at the center of the inoculated blood agar plate under the aseptic environment.
- Incubate the plate at 37⁰C overnight in the atmosphere with 5% CO₂.
- Observe the plate.
Growth in around the disc is positive result and clear zone around the disc is negative result
Alternative method using SXT blood agar
The alternative method to perform SXT susceptibility testing is using the 5% sheep blood agar with SXT. The procedure for the alternative method is as follows:
- In the aseptic environment, use a sterile inoculation loop to streak bacterial inoculum in the agar plate with SXT blood agar. The agar should have a smooth and moist surface without any moisture.
- Incubate the agar plate at 37⁰C overnight in aerobic conditions with 5% CO₂.
- Observe the plate for isolated colonies with some form of hemolysis.
Note: Further Gram staining, biochemical tests, and bacitracin sensitivity testing are necessary to confirm isolated bacteria species.
To perform SXT and Bacitracin Test Together
The procedure for performing SXT and bacitracin antibiotic susceptibility testing together is as follows:
- Using a sterile inoculating loop, perform continuous streaking on the 5% blood agar plate with the bacterial sample.
- With the help of sterile forceps, place the SXT disc in the inoculated plate, slightly off center.
- Then place the bacitracin disc 4 cm apart from the SXT disc.
- Incubate the plate at 37⁰C overnight in the atmosphere with 5% CO₂.
- Observe the plate after incubation.
Result of SXT Test
Reactions of Beta-hemolytic Streptococci to Bacitracin and SXT
| Organism | Bacitracin | SXT |
|---|---|---|
| Group A ( S. pyogenes ) | Susceptible | Resistant |
| Group B ( S. agalactiae ) | Resistant | Resistant |
| Group C, F, and G | Susceptible or Resistant | Susceptible |
The possible result of SXT and Bacitracin test together
- **Susceptible to both and susceptible to SXT but resistant to bacitracin:**Clear zone around the discs sensitive to both antibiotics. The clear zone around SXT but growth around the bacitracin disc suggests susceptibility to SXT and resistance to bacitracin. These results are possible in groups C, F and G streptococci.
- Resistant to both: Growth around both discs. For example, group B streptococci like Streptococcus agalactiae.
- Resistant to SXT and susceptible to bacitracin: Growth at the edge of SXT and clear zone around bacitracin. For example, group A streptococci like Streptococcus pyogenes.
Quality Control
Antibiotic susceptibility testing quality control requires checking the antibiotic disc with quality control strains. According to CLSI, the quality control strain for SXT-1.25/23.75 µg is Escherichia coliATCC 25922 andStaphylococcus aureusATCC 25923.
The quality control for SXT blood agar requires examining plates for product deterioration and culturing the quality control strains under CLSI guidelines.
- Streptococcus pyogenesATCC 19615 and ATCC 49117,Streptococcus agalactiaeATCC 13013– fair to heavy growth (positive control),
- Streptococcus mitisATCC 13813– no growth (negative control), and
- Neisseria subflavaATCC 14799 andNeisseria siccaATCC 9913– Partial inhibition (negative control).
References
- Leboffe, M., & Pierce, B. (2011). A photographic atlas for the microbiology laboratory (4th ed., pp. 94-95). Morton Publishing.
- BBL™ SXT Blood Agar. Legacy.bd.com. (2019). Retrieved 24 August 2022, from https://legacy.bd.com/ds/technicalCenter/inserts/L007413(09).pdf.
- CLSI guidelines M100, 30th edition.